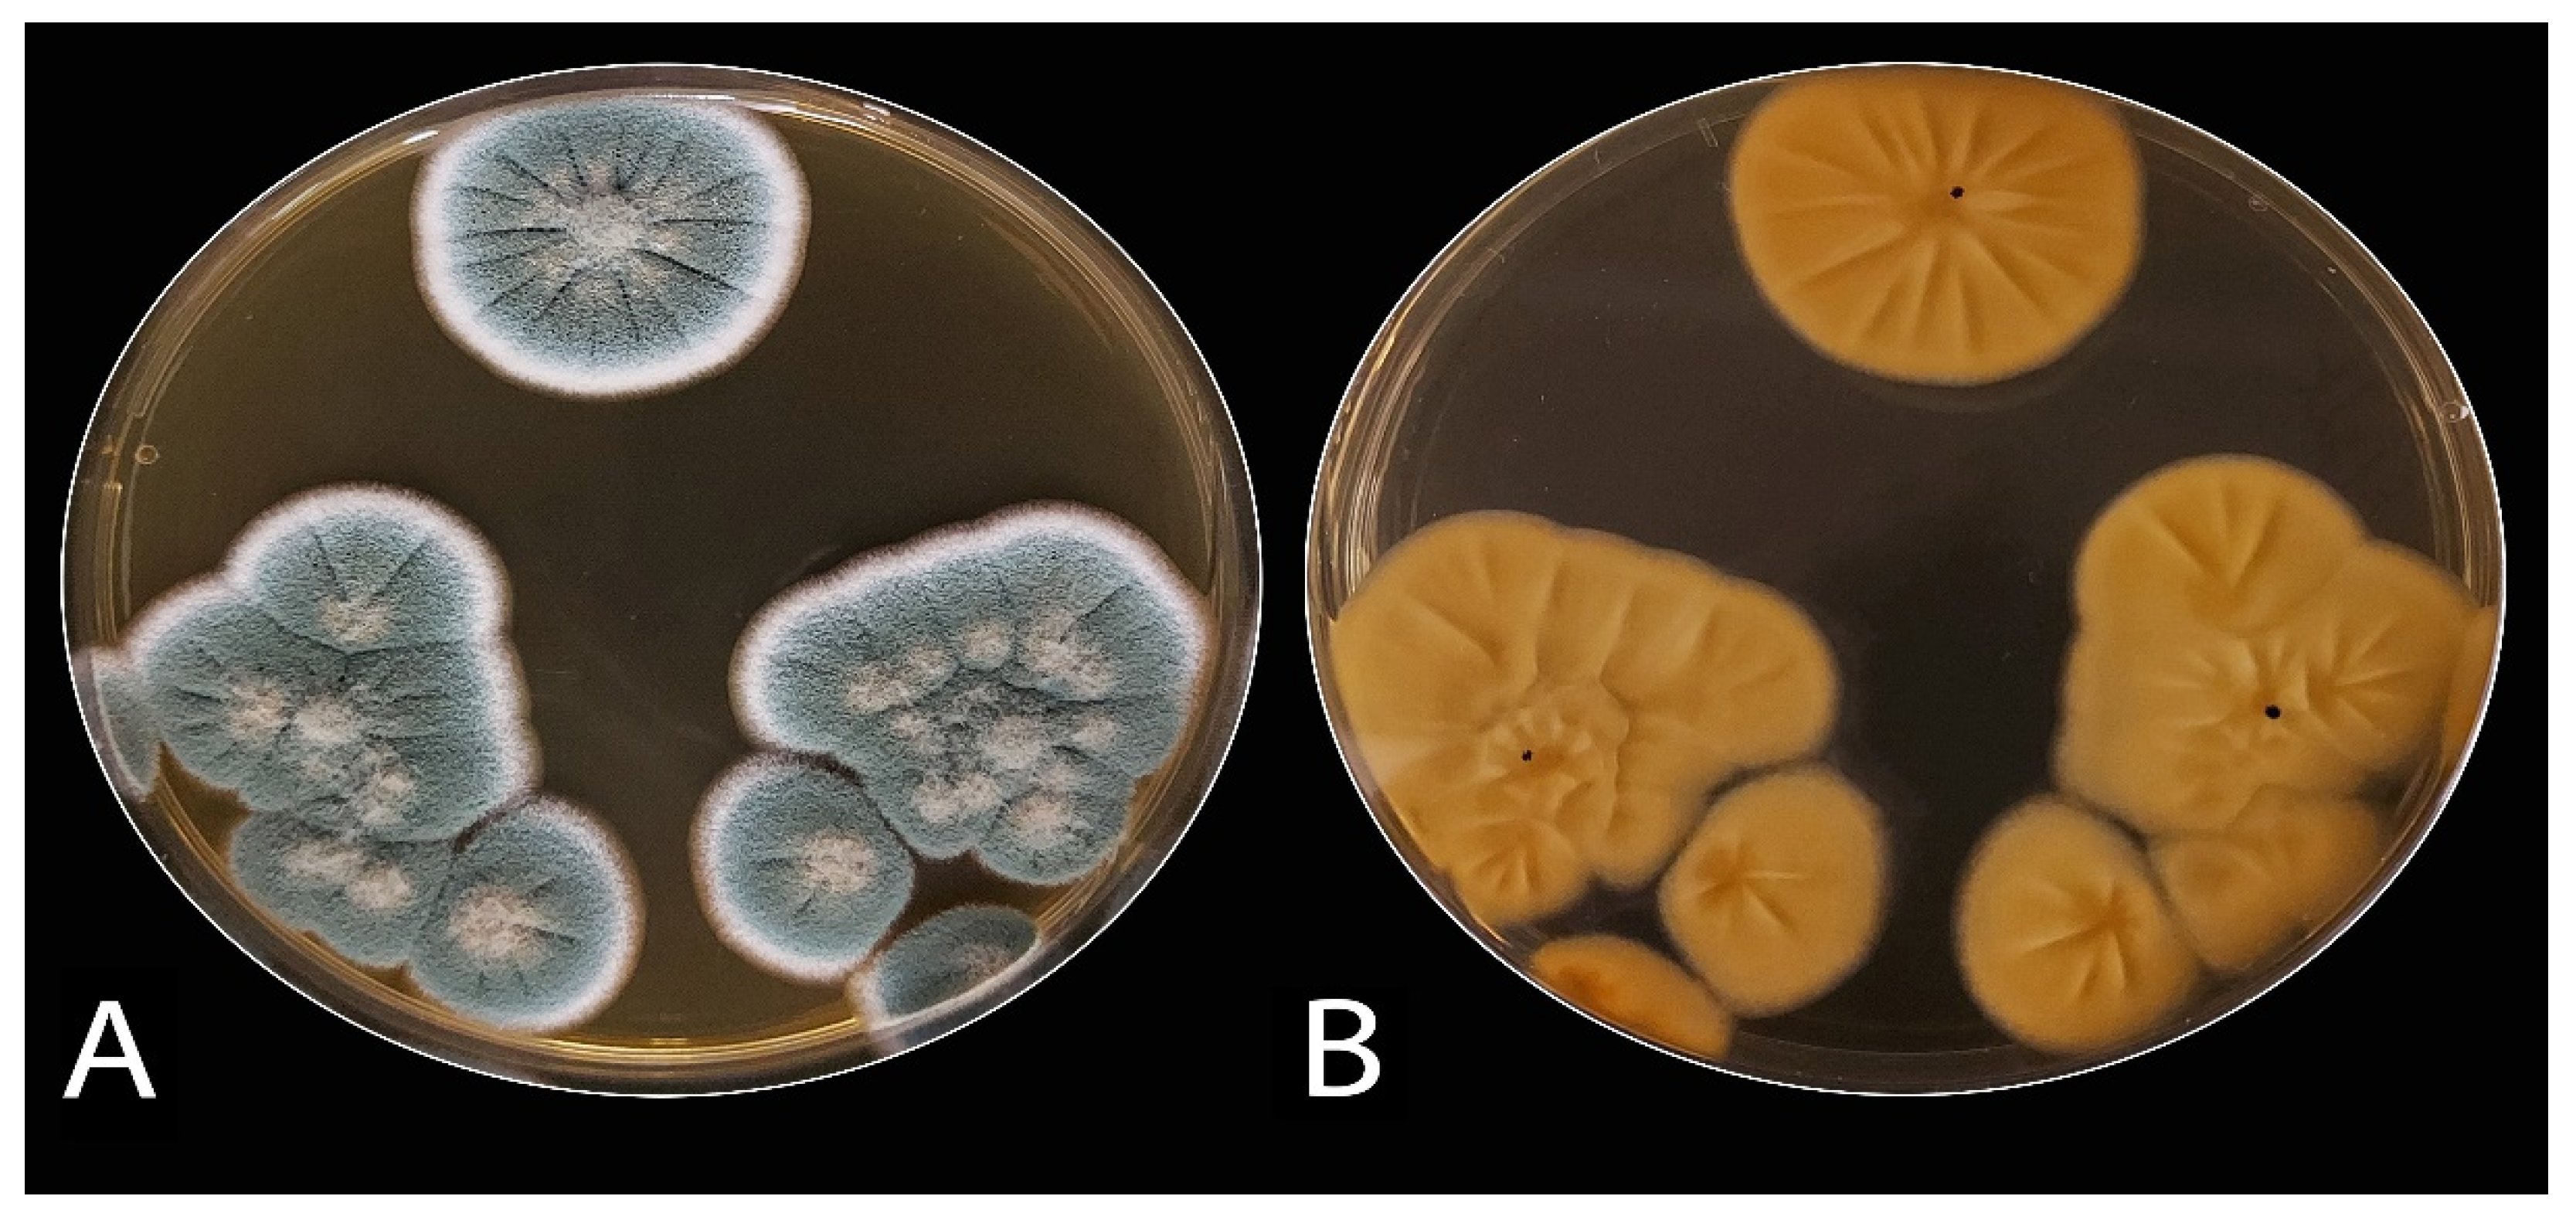
Plants 10 00413 g002

Discovering Penicillium polonicum with High-Lytic Capacity on Helianthus tuberosus Tubers: Oil-Based Preservation for Mold Management
Abstract
:1. Introduction
2. Materials and Methods
2.1. Isolation of Blue Mold
2.1.1. Fungal Purification and Identification
2.1.2. Pathogenicity Test
2.1.3. Molecular Identification
2.2. Extraction and GC Analysis of the Essential Oils
2.3. Anti-P. polonicum Activity of the Essential Oils
2.4. Enzymatic Profile of P. polonicum ARS20
2.4.1. Fermentation Conditions
2.4.2. Assay of Enzymes
2.5. Essential Oils vs. Blue Mold under Storage
2.6. Statistical Analysis
3. Results
3.1. The Blue Mold
3.1.1. Isolation, Morphological, and Microscopic Identification
3.1.2. Pathogenicity Potential of the Blue Mold
3.1.3. Molecular Identification
3.2. Essential Oils vs. P. polonicum
3.2.1. Essential Oils vs. Fungal Growth
3.2.2. GC Analysis of Caraway and Clove Oils
3.3. Enzymatic Profile of P. polonicum under Oil Stress
3.4. Essential Oils against P. polonicum under Storage
3.4.1. Disease Severity
3.4.2. Defense-Related Phytochemicals
3.4.3. The Structural Features of JA Tubers
3.4.4. Chemical Content of JA Tubers
4. Discussion
5. Conclusions
Author Contributions
Funding
Institutional Review Board Statement
Informed Consent Statement
Data Availability Statement
Conflicts of Interest
References
- Serrano, M.; Romero, D.; Guillen, F.; Valverde, J.; Zapata, P.J.; Castillo, S.; Valero, D. The addition of essential oils to MAP as a tool to maintain the overall quality of fruits. Trends Food Sci. Technol. 2008, 19, 464–471. [Google Scholar] [CrossRef]
- Du Plooy, W.; Regnier, T.; Combrinck, S. Essential oil amended coatings as alternatives to synthetic fungicides in citrus postharvest management. Postharvest Biol. Technol. 2009, 53, 117–122. [Google Scholar] [CrossRef]
- Castillo, S.; Navarro, D.; Zapata, P.J.; Guillen, F.; Valero, D.; Serrano, M.; Martínez-Romero, D. Antifungal efficacy of Aloe vera in vitro and its use as a preharvest treatment to maintain postharvest table grape quality. Postharvest Biol. Technol. 2010, 57, 183–188. [Google Scholar] [CrossRef]
- Samson, R.A.; Hoekstra, E.S.; Frisvad, J.C.; Filtenborg, O. Introduction to Food and Airborne Fungi; Centraalbureau voor Schimmelcultures (CBS): Utrecht, The Netherlands, 2004; p. 389. Available online: https://www.cabdirect.org/cabdirect/abstract/2005318.7047 (accessed on 1 October 2020).
- Chen, L.; Guo, W.; Zheng, Y.; Zhou, J.; Liu, T.; Chen, W.; Liang, D.; Zhao, M.; Zhu, Y.; Wu, Q.; et al. Occurrence and characterization of fungi and mycotoxins in contaminated medicinal herbs. Toxins 2020, 12, 30. [Google Scholar] [CrossRef] [Green Version]
- Lakíc, Ž.; Balalíc, I.; Nožiníc, M. Genetic variability for yield and yield components in Jerusalem artichoke (Helianthus tuberosus L.). Genetika 2018, 50, 45–57. [Google Scholar] [CrossRef] [Green Version]
- Bogucka, B.; Pszczółkowska, A.; Okorski, A.; Jankowski, K. The effects of potassium fertilization and irrigation on the yield and health status of Jerusalem Artichoke (Helianthus tuberosus L.). Agronomy 2021, 11, 234. [Google Scholar] [CrossRef]
- El-Awady, A.A.; Ghoneem, K.M. Natural treatments for extending storage life and inhibition fungi disease of Jerusalem artichoke fresh tubers. J. Plant Prod. Mansoura Univ. 2011, 2, 1815–1831. [Google Scholar] [CrossRef]
- Ghoneem, K.M.; Saber, W.I.A.; El-Awady, A.A.; Rashad, Y.M.; Al-Askar, A.A. Alternative preservation method against Sclerotium tuber rot of Jerusalem artichoke using natural essential oils. Phytoparasitica 2016, 44, 341–352. [Google Scholar] [CrossRef]
- Ghoneem, K.M.; Saber, W.I.A.; El-Awady, A.A.; Rashad, Y.M.; Al-Askar, A.A. Clove essential oil for controlling white mold disease, sprout suppressor and quality maintainer for preservation of Jerusalem artichoke tubers. Egypt. J. Biol. Pest Control 2016, 26, 601–608. [Google Scholar]
- Kays, S.J.; Nottingham, S.F. Biology and Chemistry of Jerusalem Artichoke: Helianthus tuberosus L.; CRC Press: London, UK, 2008; ISBN 9781420044959. [Google Scholar]
- Ezzat, A.E.S.; Ghoneem, K.M.; Saber, W.I.A.; Al-Askar, A.A. Control of wilt, stalk and tuber rots diseases using arbuscular mycorrhizal fungi, Trichoderma species and hydroquinone enhances yield quality and storability of Jerusalem artichoke (Helianthus tuberosus L.). Egypt. J. Biol. Pest Control 2015, 25, 11–22. [Google Scholar]
- Marino, M.; Bersani, C.; Comi, G. Impedance measurements to study the antimicrobial activity of essential oils from Lamiaceae and Compositae. Int. J. Food Microbiol. 2001, 67, 187–195. [Google Scholar] [CrossRef]
- Tzortzakis, N.G.; Economakis, C.D. Antifungal activity of lemongrass (Cympopogon citratus L.) essential oil against key postharvest pathogens. Innov. Food Sci. Emerg. Technol. 2007, 8, 253–258. [Google Scholar] [CrossRef]
- Mutlu-Ingok, A.; Devecioglu, D.; Dikmetas, D.N.; Karbancioglu-Guler, F.; Capanoglu, E. Antibacterial, antifungal, antimycotoxigenic, and antioxidant activities of essential oils: An updated review. Molecules 2020, 25, 4711. [Google Scholar] [CrossRef] [PubMed]
- Domsch, K.H.; Gams, W.; Anderson, T.H. Compendium of Soil Fungi; Academic Press: New York, NY, USA, 1980; Volume 1. [Google Scholar]
- Frisvad, J.C.; Samson, R.A. Polyphasic taxonomy of Penicillium subgenus Penicillium. A guide to identification of food and air-borne terverticillate Penicillia and their mycotoxins. Stud. Mycol. 2004, 49, 1–173. [Google Scholar]
- Charles, D.J.; Simon, J.E. Comparison of extraction methods for the rapid determination of essential oil content and composition of basil. J. Am. Soc. Hortic. Sci. 1990, 3, 458–462. [Google Scholar] [CrossRef] [Green Version]
- AbdAl-Aziz, S.A.A.; El-Metwally, M.M.; Saber, I.A. Molecular identification of a novel inulinolytic fungus isolated from and grown on tubers of Helianthus tuberosus and statistical screening of medium components. World J. Microb. Biot. 2012, 28, 3245–3254. [Google Scholar] [CrossRef] [PubMed]
- Saber, W.I.A.; El-Naggar, N.E.; AbdAl-Aziz, S.A. Bioconversion of lignocellulosic wastes into organic acids by cellulolytic rock phosphate-solubilizing fungal isolates grown under solid-state fermentation conditions. Res. J. Microbiol. 2010, 5, 1–20. [Google Scholar] [CrossRef] [Green Version]
- Bailey, M.J.; Beily, P.; Poutanen, K. Interlaboratory testing and methods for assay of xylanase activity. J. Biotechnol. 1992, 23, 257–270. [Google Scholar] [CrossRef]
- Kathiresan, K.; Manivannan, S. -Amylase production by Penicillium fellutanum isolated from mangrove rhizosphere soil. Afr. J. Biotechnol. 2006, 5, 829–832. [Google Scholar] [CrossRef] [Green Version]
- Bai, Z.H.; Zhang, H.X.; Qi, H.Y.; Peng, X.W.; Li, B.J. Pectinase production by Aspergillus niger using wastewater in solid state fermentation for eliciting plant disease resistance. Bioresour. Technol. 2004, 95, 49–52. [Google Scholar] [CrossRef]
- Miller, G.L. Use of dinitrosalicylic acid reagent for determination of reducing sugars. Anal. Chem. 1959, 31, 426–428. [Google Scholar] [CrossRef]
- Cupp-Enyard, C. Sigma’s non-specific protease activity assay—Casein as a substrate. J. Vis. Exp. 2008, 19, e899. [Google Scholar] [CrossRef]
- Seleim, M.A.; Abo-Elyousr, K.A.; Mohamed, A.A.A.; Al-Marzoky, H.A. Peroxidase and polyphenoloxidase activities as biochemical markers for biocontrol efficacy in the control of tomato bacterial wilt. Plant Physiol. Pathol. 2014, 2, 1–4. [Google Scholar] [CrossRef]
- Blainski, A.; Lopes, G.C.; De Mello, J.C.P. Application and analysis of the Folin Ciocalteu method for the determination of the total phenolic content from Limonium Brasiliense L. Molecules 2013, 18, 6852–6865. [Google Scholar] [CrossRef] [Green Version]
- Saengkanuk, A.; Nuchadomrong, S.; Jogloy, S.; Patanothai, A.; Srijaranai, S. A simplified spectrophotometric method for the determination of inulin in Jerusalem artichoke (Helianthus tuberosus L.) tubers. Eur. Food Res. Technol. 2011, 233, 609–616. [Google Scholar] [CrossRef]
- Albalasmeh, A.A.; Berhe, A.A.; Ghezzehei, T.A.A. new method for rapid determination of carbohydrate and total carbon concentrations using UV spectrophotometry. Carbohydr. Polym. 2013, 97, 253–261. [Google Scholar] [CrossRef]
- Bradford, M.M. A rapid and sensitive method for the quantitation of microgram quantities of protein utilizing the principle of protein-dye binding. Anal. Biochem. 1976, 72, 248–254. [Google Scholar] [CrossRef]
- Duduk, N.; Vasić, M.; Vico, I. First report of Penicillium polonicum causing blue mold on stored onion (Allium cepa) in Serbia. Plant Dis. 2014, 2014. 98, 1440. [Google Scholar] [CrossRef]
- Yin, G.; Zhang, Y.; Pennerman, K.K.; Wu, G.; Hua, S.S.T.; Yu, J.; Jurick, W.M.; Guo, A.; Bennett, J.W. Characterization of blue mold Penicillium Species isolated from stored fruits using multiple highly conserved loci. J. Fungi 2017, 3, 12. [Google Scholar] [CrossRef] [Green Version]
- Çakır, E.; Maden, S. First report of Penicillium polonicum causing storage rots of onion bulbs in Ankara province, Turkey. New Dis. Rep. 2015, 32, 24. [Google Scholar] [CrossRef] [Green Version]
- Khalil, A.M.A.; Hashem, A.H.; Abdelaziz, A.M. Occurrence of toxigenic Penicillium polonicum in retail green table olives from the Saudi Arabia market. Biocatal. Agric. Biotechnol. 2019, 21, 101314. [Google Scholar] [CrossRef]
- Wang, C.W.; Ai, J.; Lv, H.Y.; Qin, H.Y.; Yang, Y.M.; Liu, Y.X.; Fan, S.T. First report of Penicillium expansum causing postharvest decay on stored kiwifruit (Actinidia arguta) in China. Plant Dis. 2015, 99, 1037. [Google Scholar] [CrossRef]
- Inglis, P.W.; Tigano, M.S. Identification and taxonomy of some entomopathogenic Paecilomyces spp. (Ascomycota) isolates using rDNA-ITS sequences. Genet. Mol. Biol. 2006, 29, 132–136. [Google Scholar] [CrossRef] [Green Version]
- Gardes, M.; Bruns, T.D. ITS primers with enhanced specificity for basidiomycetes-application to the identification of mycorrhizae and rusts. Mol. Ecol. 1993, 2, 113–118. [Google Scholar] [CrossRef] [PubMed]
- Raja, H.A.; Miller, A.N.; Pearce, C.J.; Oberlies, N.H. Fungal identification using molecular tools: A primer for the natural products research community. J. Nat. Prod. 2017, 80, 756–770. [Google Scholar] [CrossRef]
- Schoch, C.L.; Seifert, K.A.; Huhndorf, S.; Robert, V.; Spouge, J.L.; Levesque, C.A.; Chen, W. Fungal Barcoding Consortium. Nuclear ribosomal internal transcribed spacer (ITS) region as a universal DNA barcode marker for Fungi. Proc. Natl. Acad. Sci. USA 2012, 109, 6241–6246. [Google Scholar] [CrossRef] [Green Version]
- Combrinck, S.; Regnier, T.; Kamatou, G.P.P. In vitro activity of eighteen essential oils and some major components against common postharvest fungal pathogens of fruit. Ind. Crops Prod. 2011, 33, 344–349. [Google Scholar] [CrossRef]
- Salha, G.B.; Díaz, R.H.; Lengliz, O.; Abderrabba, M.; Labidi, J. Effect of the chemical composition of free-Terpene hydrocarbons essential oils on antifungal activity. Molecules 2019, 24, 3532. [Google Scholar] [CrossRef] [Green Version]
- Ibrahim, G.S.; Kiki, M.J. Chemical composition, antifungal and antioxidant activity of some spice essential oils. Int. J. Life Sci. Pharma Res. 2020, 10, 43–50. [Google Scholar] [CrossRef]
- Darougheh, F.; Barzegar, M.; Sahari, M.A. Antioxidant and anti-fungal effect of caraway (Carum carvi L.) essential oil in real food system. Curr. Nutr. Food Sci. 2014, 10, 70–76. [Google Scholar] [CrossRef]
- Burt, S. Essential oils: Their antibacterial properties and potential applications in foods-a review. Int. J. Food Microbiol. 2004, 94, 223–253. [Google Scholar] [CrossRef] [PubMed]
- Kubicek, C.P.; Starr, T.L.; Glass, N.L. Plant cell wall–degrading enzymes and their secretion in plant-pathogenic fungi. Annu. Rev. Phytopathol. 2014, 52, 427–451. [Google Scholar] [CrossRef] [PubMed]
- Badhan, A.K.; Chadha, B.S.; Kaur, J.; Saini, H.S.; Bhat, M.K. Production of multiple xylanolytic and cellulolytic enzymes by thermophilic fungus Myceliophthora sp. IMI 387099. Biores. Technol. 2007, 98, 504–510. [Google Scholar] [CrossRef] [PubMed]
- Saber, W.I.A.; El-Naggar, N.E.; El-Hersh, M.S.; El-Khateeb, A.Y. An innovative synergism between Aspergillus oryzae and Azotobacter chroococcum for bioconversion of cellulosic biomass into organic acids under restricted nutritional conditions using multi-response surface optimization. Biotechnology 2015, 14, 47–57. [Google Scholar] [CrossRef] [Green Version]
- Caufrier, F.; Martinou, A.; Dupont, C.; Bouriotis, V. Carbohydrate esterase family 4 enzymes: Substrate specificity. Carbohydr. Res. 2003, 338, 687–692. [Google Scholar] [CrossRef]
- Tuoping, L.; Wang, N.; Li, S.; Zhao, Q.; Guo, M. Optimization of covalent immobilization of pectinase on sodium alginate support. Biotechnol. Lett. 2007, 29, 1413–1416. [Google Scholar] [CrossRef]
- Saranraj, P.; Stella, D. Fungal amylase—A review. Int. J. Microbiol. Res. 2013, 4, 203–211. [Google Scholar] [CrossRef]
- Ohta, K.; Suetsugu, N.; Nakamura, T. Purification and properties of an extracellular inulinase from Rhizopus sp. Strain TN-96. J. Biosci. Bioeng. 2002, 1, 78–80. [Google Scholar] [CrossRef]
- Saber, W.I.A.; El-Naggar, N.E. Optimization of fermentation conditions for the biosynthesis of inulinase by the new source; Aspergillus tamarii and hydrolysis of some inulin containing agro-wastes. Biotechnology 2009, 8, 425–433. [Google Scholar] [CrossRef]
- El-Hersh, M.S.; Saber, W.I.A.; El-Naggar, N.E. Production strategy of inulinase by Penicillium citrinum AR-IN2 on some agricultural by-products. Microbiol. J. 2011, 1, 79–88. [Google Scholar] [CrossRef]
- El-Hersh, M.S.; Saber, W.I.; El-Fadaly, H.A. Amino acids associated with optimized alkaline protease production by Bacillus subtilis ATCC 11774 using statistical approach. Biotechnology 2014, 13, 252–262. [Google Scholar] [CrossRef]
- Gurumallesh, P.; Alagu, K.; Ramakrishnan, B.; Muthusamy, S. A systematic reconsideration on proteases. Int. J. Biol. Macromol. 2019, 128, 254–267. [Google Scholar] [CrossRef]
- Afify, A.M.R.; El-Beltagi, H.S.; Aly, A.A.; El-Ansary, A.E. Antioxidant enzyme activities and lipid peroxidation as biomarker for potato tuber stored by two essential oils from caraway and clove and its main component carvone and eugenol. Asian Pac. J. Trop. Biomed. 2012, S772–S780. [Google Scholar] [CrossRef]
- Børsheim, K.Y.; Christensen, B.E.; Painter, T.J. Preservation of fish by embedment in Sphagnum moss, peat or holocellulose: Experimental proof of the oxopolysaccharidic nature of the preservative substance and of its antimicrobial and tanning action. Innov. Food Sci. Emerg. Technol. 2001, 2, 63–74. [Google Scholar] [CrossRef]
- Taskila, S.; Särkelä, R.; Tanskanen, J. Valuable applications for peat moss. Biomass Conv. Bioref. 2016, 6, 115–126. [Google Scholar] [CrossRef]
- Cabezas, M.J.; Rabert, C.; Bravo, S.; Shene, C. Inulin and sugar contents in Helianthus tuberosus and Cichorium intybus tubers: Effect of postharvest storage temperature. J. Food Sci. 2002, 67, 2860–2865. [Google Scholar] [CrossRef]
- Şanlı, A.; Karadoğan, T. Carvone containing essential oils fas sprout suppressants in potato (Solanum tuberosum L.) tubers at different storage temperatures. Potato Res. 2019, 62, 345–360. [Google Scholar] [CrossRef]
- Gómez-Castillo, D.; Cruz, E.; Iguaz, A.; Arroqui, C.; Vírseda, P. Effects of essential oils on sprout suppression and quality of potato cultivars. Postharvest Biol. Technol. 2013, 82, 15–21. [Google Scholar] [CrossRef]
- Oosterhaven, K.; Hartmans, K.J.; Scheffer, J.J.C. Inhibition of potato sprout growth by carvone enantiomers and their bioconversion in sprouts. Potato Res. 1995, 38, 219–230. [Google Scholar] [CrossRef]
- Finger, F.L.; Santos, M.M.S.; Araujo, F.F.; Lima, P.C.C.; da Costa, L.C.; França, C.F.M.; Queiroz, M.C. Action of essential oils on sprouting of non-dormant potato tubers. Braz. Arch. Biol. Technol. 2018, 61, e18180003. [Google Scholar] [CrossRef] [Green Version]
- Santos, M.N.S.; Araujo, F.F.; Lima, P.C.C.; Costa, L.C.; Finger, F.L. Changes in potato tuber sugar metabolism in response to natural sprout suppressive compounds. Acta Scientiarum. Agron. 2020, 42, e43234. [Google Scholar] [CrossRef] [Green Version]
- Al-Snafi, A.E. Medical importance of Helianthus tuberosus—A review. Indo Am. J. Pharm. Sci. 2018, 05, 2159–2166. [Google Scholar] [CrossRef]

| Oil | Peak Number | Compound | Retention Time | Peak Area% | Chemical Structure of Major Oil |
|---|---|---|---|---|---|
| Clove | 1 | Methyl salicylate | 6.928 | 19.274 |  Eugenol |
| 2 | Bicyclobutylidiene | 7.645 | 3.084 | ||
| 3 | Eugenol | 11.080 | 49.077 | ||
| 4 | Eugenyl acetate | 11.603 | 11.551 | ||
| 5 | Farnesene | 11.957 | 3.324 | ||
| * | Unidentified compounds | 3.950 | 4.473 | ||
| * | 5.879 | 2.542 | |||
| * | 6.479 | 6.675 | |||
| Total | 100 | ||||
| Caraway | 1 | Limonene | 3.670 | 35.265 |  Carvone |
| 2 | Carvone | 9.469 | 60.398 | ||
| 3 | Perilla alcohol | 9.707 | 1.430 | ||
| 4 | Carveol | 2.088 | 1.106 | ||
| * | Unidentified compounds | 3.125 | 0.822 | ||
| * | 1.319 | 0.063 | |||
| * | 10.223 | 0.916 | |||
| Total | 100 | ||||
| Oil, % | FPase | Xylanase | PGase | Protease | Amylase | Inulinase | Invertase | |
|---|---|---|---|---|---|---|---|---|
| 0.0 | 17.62 ± 0.31 | 28.11 ± 1.04 | 38.71 ± 2.22 | 23.6 ± 3.33 | 56.6 ± 3.21 | 5.18 ± 1.81 | 0.93 ± 0.11 | |
| Clove | 0.5 | 2.96 ± 0.22 | 23.28 ± 1.23 | 10.54 ± 1.94 | 23.59 ± 4.06 | 15.46 ± 2.34 | 4.92 ± 2.65 | 0.25 ± 0.11 |
| 1.0 | 0.00 | 20.20 ± 0.97 | 8.74 ± 2.04 | 23.57 ± 2.55 | 11.59 ± 2.68 | 4.92 ± 1.54 | 0.24 ± 0.09 | |
| 1.5 | 0.00 | 16.25 ± 0.99 | 8.03 ± 1.55 | 21.63 ± 3.26 | 11.14 ± 1.45 | 4.87 ± 1.55 | 0.24 ± 0.08 | |
| 2.0 | ND | ND | ND | ND | ND | ND | ND | |
| 2.5 | ND | ND | ND | ND | ND | ND | ND | |
| Caraway | 0.5 | 12.27 ± 0.44 | 0.00 | 18.97 ± 2.03 | 16.61 ± 3.52 | 32.96 ± 3.35 | 5.14 ± 0.62 | 0.27 ± 0.15 |
| 1.0 | 8.30 ± 0.29 | 0.00 | 16.29 ± 1.05 | 15.00 ± 2.58 | 26.14 ± 2.56 | 5.00 ± 0.76 | 0.25 ± 0.13 | |
| 1.5 | 0.00 | 0.00 | 8.24 ± 2.21 | 13.76 ± 2.48 | 5.00 ± 1.02 | 4.95 ± 0.56 | 0.25 ± 0.09 | |
| 2.0 | ND | ND | ND | ND | ND | ND | ND | |
| 2.5 | ND | ND | ND | ND | ND | ND | ND | |
| Treatment | Storage Time (Month) | |||
|---|---|---|---|---|
| 1 | 2 | 3 | 4 | |
| C | 18.1 ± 6.1 | 30.6 ± 3.5 | 57.9 ± 1.2 | 76.4 ± 1.9 |
| P | 48.3 ± 3.2 | 73.4 ± 5.1 | ND | ND |
| CR | 0.0 | 0.0 | 0.0 | 0.0 |
| CL | 0.0 | 0.0 | 0.0 | 0.0 |
| CRP | 0.0 | 0.0 | 0.0 | 0.0 |
| CLP | 9.5 ± 3.7 | 22.4 ± 3.8 | 45.5 ± 3.3 | 64.3 ± 3.5 |
Publisher’s Note: MDPI stays neutral with regard to jurisdictional claims in published maps and institutional affiliations. |
© 2021 by the authors. Licensee MDPI, Basel, Switzerland. This article is an open access article distributed under the terms and conditions of the Creative Commons Attribution (CC BY) license (http://creativecommons.org/licenses/by/4.0/).
Share and Cite
Al-Askar, A.A.; Rashad, E.M.; Ghoneem, K.M.; Mostafa, A.A.; Al-Otibi, F.O.; Saber, W.I.A. Discovering Penicillium polonicum with High-Lytic Capacity on Helianthus tuberosus Tubers: Oil-Based Preservation for Mold Management. Plants 2021, 10, 413. https://doi.org/10.3390/plants10020413
Al-Askar AA, Rashad EM, Ghoneem KM, Mostafa AA, Al-Otibi FO, Saber WIA. Discovering Penicillium polonicum with High-Lytic Capacity on Helianthus tuberosus Tubers: Oil-Based Preservation for Mold Management. Plants. 2021; 10(2):413. https://doi.org/10.3390/plants10020413
Chicago/Turabian StyleAl-Askar, Abdulaziz A., Ehsan M. Rashad, Khalid M. Ghoneem, Ashraf A. Mostafa, Fatimah O. Al-Otibi, and WesamEldin I. A. Saber. 2021. "Discovering Penicillium polonicum with High-Lytic Capacity on Helianthus tuberosus Tubers: Oil-Based Preservation for Mold Management" Plants 10, no. 2: 413. https://doi.org/10.3390/plants10020413
APA StyleAl-Askar, A. A., Rashad, E. M., Ghoneem, K. M., Mostafa, A. A., Al-Otibi, F. O., & Saber, W. I. A. (2021). Discovering Penicillium polonicum with High-Lytic Capacity on Helianthus tuberosus Tubers: Oil-Based Preservation for Mold Management. Plants, 10(2), 413. https://doi.org/10.3390/plants10020413







